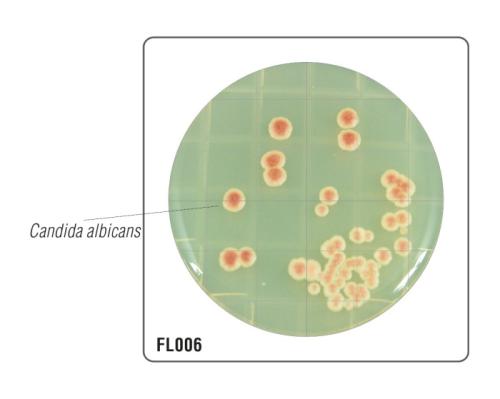
HiTouch™ Yeast and Mould Count FlexiPlate™ для подсчета дрожжей и плесени FL006

HiTouch™ Yeast and Mould Count FlexiPlate™ для подсчета дрожжей и плесени
HiTouch™ Yeast and Mould Count FlexiPlate™ for enumeration of yeast & mould (fungal) population
Характеристики
Тип
Гибкие пластины с питательной средой
Упаковка
50
Общие характеристики
- Внешний вид: Стерильный формованный футляр, содержащая прозрачный или слегка опалесцирующий плотный гель светло-желтого цвета.
- Кол-во среды: 9 мл
- Реакция среды: рН 5,6 ± 0,2.
- Тест на стерильность: Стерильность среды проверялась в течение 14 дней. Результат: стерильная среда без образования колоний на поверхности агара.
- Реакция культуры: Характерные культуры микроорганизмов наблюдаются после инкубации при 22-28°C в течение 48-72 часов.
Запросить стоимость
Описание
- Для подсчета количества дрожжей и плесени в воздухе и на поверхности;
- Можно увидеть колонии, цвет которых варьируется от розового до красного из-за присутствия индикаторного красителя;
- Среда способствует образованию аскоспор;
- Кислотный pH способствует селективному росту дрожжей и плесени;
- Температура инкубации 22-28 °С;
- Результаты в течение 48-72 часов.
| Организмы (ATCC) (WDCM*) | Рост | Цвет колонии |
|---|---|---|
| C. albicans (ATCC 10231) (00054*) | активный | розовато-белый |
| S. cerevisiae (ATCC 9763) (00058*) | активный | розовато-белый |
Состав:
| Ингредиенты | г/л |
|---|---|
| Картофельный настой | 200.00 |
| Декстроза | 20.00 |
| Индикаторный краситель | 0.03 |
| Агар | 15.00 |
Характеристики
Области применения
- Косметическая и фармацевтическая промышленность - для проверки воздуха и поверхности;
- Пищевая промышленность - для определения общего количества аэробных веществ в продуктах, а также для проверки воздуха и поверхности;
- Вода и сточные воды - для лабораторий по проверке воздуха и поверхности;
- Птицеводство и мясная промышленность - для определения общего количества аэробных веществ в продуктах, а также для проверки воздуха и поверхности;
- Больница/операционная – для проверки воздуха и поверхности;
- Прочие лаборатории, в которых проводятся работы в области микробиологии.
Документация
HiMedia Laboratories Pvt. Ltd. - абсолютный лидер по ассортименту поставляемых питательных сред.